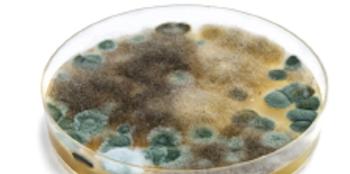

Palace Drug Store owner Hannah Taylor and her employees go above and beyond to help patients.
Karen Berger, PharmD, graduated from the University of Pittsburgh School of Pharmacy in 2001. She has worked in community pharmacies for over 17 years as a Pharmacist in Charge, staff, and floater pharmacist for a large chain. Currently, she is a pharmacist at an independent pharmacy in Northern NJ. She can be reached at karenmichelleberger@gmail.com

Palace Drug Store owner Hannah Taylor and her employees go above and beyond to help patients.

The importance of a team-based approach including pharmacy staff in performing medication reconciliation during a transition of care for patients being discharged from the hospital.
Before the bacteria killer’s introduction, there were no effective treatments for infections.

Two pharmacies and a family medicine practice serve many who lack transportation, offering free delivery in 9 counties.

Pharmacists should refer patients to a health care provider if any symptoms could be indicative of a GIST.

Can nitroglycerin patches be used to treat tendonitis?

The Colorado business is expanding, offering animal and human compounding, as well as flu, hormone, pharmacogenomics, and strep testing.

The medical pioneer never patented or profited from his work that saved untold numbers of lives.

Flip the Pharmacy helps pharmacy teams provide enhanced clinical services for their patients and has developed a COVID-19 best practices program.

Curriculum may improve the profession of pharmacy and enhance the way pharmacists provide patient care.

Can donepezil be the cause of abnormal dreams?

The Ivy League university’s College of Pharmaceutical Sciences had provided education for nearly 150 years.

Bintz, a second-generation Oklahoma business, offers clinical and compounding services and boasts a service-focused model and staff.

Why is guaifenesin being used for fertility?

Why is your patient using conjugated estrogens vaginal cream for nosebleeds?

Several pharmaceutical companies are racing to develop an effective treatment for the virus that is now a global pandemic.

Could losartan be the cause of insomnia?

Why is a patient taking cimetidine for warts?

Why is KM taking such a high dose of prednisone?

Why is your patient using clonazepam for burning mouth syndrome?

Four Corners Pharmacy offers a personalized touch while using the newest technology and leading clinical initiatives.

In the 19th and 20th centuries, druggists made and marketed their own secret formulas.

A patient comes into your pharmacy holding a piece of paper for liquid docusate. What should you do?

Why is DT, a female patient, taking finasteride?

Why is AR experiencing vision disturbances?

Why does a patient's levothyroxine dose need to be adjusted?

Hemophagocytic lymphohistiocytosis (HLH) induced by lamotrigine was recently an active topic on social media, with users following a recent article that reported an Austin, Texas detective had died from the condition in 2018.

Could tadalafil be causing a patient to feel dizzy?

What is causing a patient’s memory loss?

Located in a remote area of Florida, the business offers delivery and after-hours service for its community.